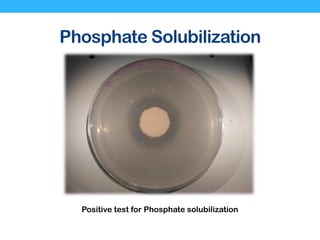
Phosphate Solubilization
Positive test for Phosphate solubilization

The document discusses a research collaboration on the genome sequencing of Bacillus thuringiensis MCMy1 in relation to acid mine drainage at the Mamut copper mine in Sabah, Malaysia. Key research questions involve investigating genetic mechanisms for adaptation, evidence of horizontal gene transfer, and features associated with metal tolerance. The study includes microbial isolation and characterization, genome sequencing, and concludes that the genome encodes genes for exo-polysaccharide biosynthesis without evidence of plasmids.